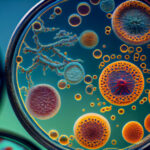
microbiome-friendly haircare

Everything about
Hair
Latest
Top trending
5 min read
Struggling with oily scalp and dry ends? Discover causes, expert tips, and solutions to balance oil, hydrate ends, and keep your hair healthy.
Editor’s Choice
Lorem ipsum dolor sit amet
Integer quis faucibus turpis. Maecenas condimentum blandit ipsum. Pellentesque eget sollicitudin nisi, eu pretium justo.
All posts
5 min read
Confused by hair product labels? Learn how to read ingredients, avoid harmful chemicals, and choose the best products for
5 min read
Coloring virgin hair is a huge decision to make. It’s your first time coloring your hair. Taking that plunge
5 min read
Learn what virgin hair is, how to tell if hair is virgin, and expert tips for caring for virgin
5 min read
Do you want to enhance your style with hair extensions? Learn all the tricks here to hide hair extensions
5 min read
Discover the magic of air-touch highlights. Learn how this technique works, benefits, tips, and how to get natural-looking highlights
5 min read
The short answer to is shampoo bad for your hair is no. But it does depend on what type
5 min read
Learn step-by-step techniques for cutting curly hair from layering, tips to expert advice to avoid shrinkage and maintain curl
5 min read
Did you know that when it comes to hair loss and sugar there is a link? Learn here how
5 min read
Discover how scalp treatment for hair loss works, its benefits, and tips to boost hair growth. Learn techniques and
Subscribe to learn more about Category 1
By clicking “Subscribe” you agree to Haste Privacy Policy and consent to Haste using your contact data for newsletter purposes